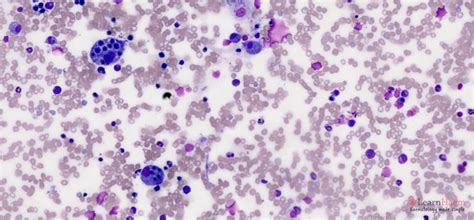
histoplasmosis histoplasma

Understanding Histoplasmosis Disease
Histoplasmosis FAQ
Where does histoplasmosis occur?
In the United States, histoplasmosis commonly occurs in the Mississippi and Ohio River valleys. But it can occur in other areas, too. It also occurs in Africa, Asia, Australia, and in parts of Central and South America. Most people with histoplasmosis never develop symptoms and aren't aware they're infected.
What is histoplasmosis fungus?
Histoplasmosis is an infection caused by breathing in spores of a fungus often found in bird and bat droppings. People usually get it from breathing in these spores when they become airborne during demolition or cleanup projects.
How do people get histoplasmosis?
People usually get it from breathing in these spores when they become airborne during demolition or cleanup projects. Soil contaminated by bird or bat droppings also can spread histoplasmosis, putting farmers and landscapers at a higher risk of the disease.
What is acute histoplasmosis?
Acute, or short-term, histoplasmosis is typically mild. It rarely leads to complications. The Centers for Disease Control and Prevention (CDC) estimate that between 60 and 90 percent of people who live in areas where the fungus is common have been exposed. Many of these people probably did not have any symptoms of infection.
What causes histoplasmosis?
Histoplasmosis is caused by the reproductive cells (spores) of the fungus Histoplasma capsulatum. They float into the air when dirt or other material is disturbed. The fungus thrives in damp soil that's rich in organic material, especially the droppings from birds and bats.
How dangerous is histoplasmosis?
One of the most dangerous aspects of histoplasmosis is severe lung infections. Cases of Histoplasma pneumonia can be deadly. In some people, histoplasmosis hides in the body for months or years. The fungus may show up and cause another infection years later (called a relapse of infection).
Where is Histoplasma found?
The Histoplasma organism is found in soil with high organic content and undisturbed bird and bat droppings, for example in and around old chicken houses, bat caves and pigeon roosts. People usually become infected with histoplasmosis after breathing in the microscopic fungal spores from the air.
Histoplasmosis References
If you want to know more about Histoplasmosis, consider exploring links below:
What Is Histoplasmosis
- https://www.mayoclinic.org/diseases-conditions/histoplasmosis/symptoms-causes/syc-20373495
- https://my.clevelandclinic.org/health/diseases/24811-histoplasmosis
- https://www.verywellhealth.com/histoplasmosis-7111772
- https://en.wikipedia.org/wiki/Histoplasmosis
- https://www.cdc.gov/fungal/diseases/histoplasmosis/index.html
- https://www.healthline.com/health/histoplasmosis
- https://www.msdmanuals.com/en-au/professional/infectious-diseases/fungi/histoplasmosis
- https://www.medicalnewstoday.com/articles/318078
Histoplasmosis Information
Explore Related Topics
Are telemedicine consultations a reliable alternative for diagnosing and treating fungal infections?
Evaluate the reliability of telemedicine for diagnosing and treating fungal infections and share your insights on this topic.